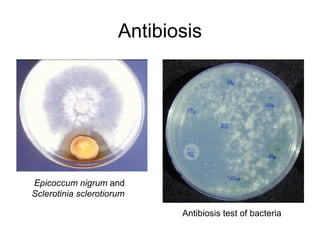
Antibiosis Epicoccum nigrum  and  Sclerotinia sclerotiorum   Antibiosis test of bacteria

1. Ecology is the study of the relationships between living things and their environment. It includes the relationships between species as well as their interactions with abiotic environmental factors.
2. There are several subfields of ecology including plant ecology, animal ecology, microbial ecology, and environmental science which focuses on environmental protection.
3. Ecology is applied in various medical fields to understand the genetic and environmental causes of diseases and their transmission. Key ecological concepts like populations, ecosystems, food webs, and interspecific relationships are important in medicine.